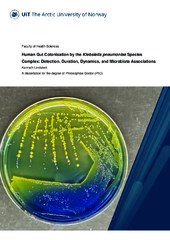

Doktorgradsavhandlinger (Helsefak): Nye registreringer
Viser treff 61-80 av 770
-
Intracranial artery disease in the general population
(Doctoral thesis; Doktorgradsavhandling, 2024-06-18)Intracranial aneurysms (IAs) and intracranial artery stenoses (ICAS) are vascular conditions of the brain that can lead to stroke. An IA is an outpouching of the artery wall that can rupture, causing an aneurysmal subarachnoid hemorrhage (aSAH), a severe form of stroke with high mortality and potential for disability. ICAS involves narrowing of brain arteries, commonly due to atherosclerosis, which ... -
Exploring Staphylococcus aureus Adaptation in In vitro Colonization and Infection Models: A Transcriptomics Approach
(Doctoral thesis; Doktorgradsavhandling, 2024-06-14)Individuals colonized by <i>S. aureus</i>, face a higher risk of <i>S. aureus</i> infections compared to non-carriers, and some throat carriers are prone to recurrent colonization even after antibiotic treatment. While <i>S. aureus</i> nasal colonization is well-studied, there is limited information about throat colonization. Our research aims to address this knowledge gap by exploring <i>S. aureus</i> ... -
From student to professional – mastering the necessary non-technical skills. Assessment tools and effects of multi-professional simulation training
(Doctoral thesis; Doktorgradsavhandling, 2024-06-14)Non-technical skills include important skills such as communication, decision making, situational awareness and teamwork. Together with medical knowledge, these constitute the basic competence that all doctors must possess. This thesis takes a closer look at Norwegian medical students' non-technical skills. This thesis consists of three articles. In the first article, the necessary non-technical ... -
Long non-coding RNAs in ulcerative colitis
(Doctoral thesis; Doktorgradsavhandling, 2024-06-12)Ulcerative colitis (UC) is a chronic inflammatory condition of the large intestine, influenced by various factors such as genetics, environment, gut contents, and the host's immune system. It has been reported that epigenetic factors, such as long non-coding RNAs (lncRNAs) and DNA methylation, play a role in UC development. The contribution of lncRNAs to UC pathogenesis is not fully understood. ... -
Encouraging participation in physical activity for individuals with intellectual disability: motivational factors, barriers, and mHealth applications
(Doctoral thesis; Doktorgradsavhandling, 2024-06-11)This thesis focuses on participation in physical activity among adults with intellectual disabilities. The aim is to explore motivation, the use of mobile health applications, and identify barriers to participation in physical activity. The thesis sought to understand why some individuals engage in physical activity while others do not, and how technology can help increase activity levels. In the ... -
Human Gut Colonisation by the Klebsiella pneumoniae Species Complex: Detection, Duration, Dynamics, and Microbiota Associations
(Doctoral thesis; Doktorgradsavhandling, 2024-06-10)The Klebsiella pneumoniae Species Complex (KpSC) is an important group of human pathogens, of which, Klebsiella pneumoniae is most clinically important and frequently associated with antimicrobial resistance (AMR). K. pneumoniae gastrointestinal tract (GIT) colonisation is a key infection risk factor and hub for AMR dissemination. Here we investigated and compared the ZKIR-qPCR and whole metagenomic ... -
How Religion and Spirituality Impact Mental Health and Mental Help-Seeking Behavior in Arctic Norway: an Epidemiological Study Adopting the SAMINOR 2 Questionnaire Survey
(Doctoral thesis; Doktorgradsavhandling, 2024-06-07)<p><i>Objectives:</i> Most international studies have shown that religion and spirituality (R/S) are related to better mental health, yet the Indigenous Sámi—being more committed to R/S than the majority population in the area—have poorer mental health and are more inclined toward suicidal behavior. Laestadianism—an important R/S factor for these people and this region—is related to poorer mental ... -
Towards personalized medicine in ulcerative colitis. Long-term follow-up after biological treatment and prediction of clinical outcomes
(Doctoral thesis; Doktorgradsavhandling, 2024-06-20)Ulcerøs kolitt (UC) er en kronisk tarmsykdom kjennetegnet med betennelse i tykktarmen som forårsaker symptomer som magesmerter, blodig avføring og diaré. Å forstå årsakene til UC er utfordrende og involverer en kompleks blanding av faktorer som immunsystemproblemer, eksponering for mikrober og genetiske påvirkninger. Et gjennombrudd i UC-behandling kom med anti-tumor nekrose faktor (anti-TNF) ... -
Finnmark mellom frigjøring og fred. Livsvilkår blant overvintrere fra 25. oktober 1944 til 8. mai 1945
(Doctoral thesis; Doktorgradsavhandling, 2024-06-14)Finnmark mellom frigjøring og fred. Livsvilkår blant overvintrere fra 25. oktober 1944 til 8. mai 1945. Den 18. oktober 1944 krysset sovjetiske styrker grensen til Norge i Sør-Varanger. Etter en uke med kamper på norske jord, lyktes sovjeterne å presse de tyske soldatene på retrett. Den første delen av Norge var fritt etter nesten fem års okkupasjon den 25. oktober 1944. Samtidig forberedte ... -
Plasma von Willebrand factor and risk of future venous thromboembolism
(Doctoral thesis; Doktorgradsavhandling, 2024-05-31)Venous thromboembolism (VTE), an umbrella term for deep vein thrombosis (DVT) and pulmonary embolism (PE), is a common disease with serious complications. Meanwhile, the exact underlying mechanisms remain unclear. Von Willebrand factor (VWF) is pivotal in haemostasis, and likely causally involved in VTE. VWF is regulated by ADAMTS13 and can promote haemostasis in two distinct ways; i.e., interaction ... -
An investigation of BK Polyomavirus replication in tubular epithelial cells: New insights into kidney dissemination and neutralising antibodies
(Doctoral thesis; Doktorgradsavhandling, 2024-05-24)BK Polyomavirus (BKPyV) infects most humans and causes an unnoticed lifelong infection of kidney epithelial cells. In immunosuppressed kidney transplant recipients, unchecked high-level BKPyV replication causes BKPyV nephropathy, a disease leading to reduced allograft function and premature allograft loss. The aim of this thesis was to learn more about BKPyV replication and dissemination, as such ... -
The role of cognitive effort in decision-making and reasoning errors. Reasoning errors: Beyond insufficient effort - implicating the Locus Coeruleus - Norepinephrine system
(Doctoral thesis; Doktorgradsavhandling, 2024-05-24)Cognitive effort is highly familiar in everyday life and may influence our decisions and task performance. However, researchers have struggled to both define and measure cognitive effort. A range of tools measuring cognitive effort has been developed within different lines of research. Yet it is unclear to what degree these tools are related and if they are measuring the same cognitive effort ... -
ATG8s in the nucleus: Beyond the autophagy paradigm
(Doctoral thesis; Doktorgradsavhandling, 2024-05-23)Selective autophagy is responsible for the lysosomal degradation of damaged or unnecessary cellular components, via a mechanism that acts in the cytoplasm. This process is crucial for cellular health and the responses to stress. In this study, we looked at a specific group of proteins, called ATG8s, which according to published literature, acts along with the selective autophagy receptors as the ... -
The Influence of Verbal Instructions on Action Control
(Doctoral thesis; Doktorgradsavhandling, 2024-04-26)Prior research on action control has primarily focused on action-effect learning through behavioral experiments. However, another line of research has demonstrated that verbal information can serve as an alternative route for forming these associations, even without any active behavior. This thesis explores whether verbal instructions framed in an effect-response manner can provide an additional ... -
Trends for cognitive function and dementia in a general population; Risk factors, trajectories, and incidence
(Doctoral thesis; Doktorgradsavhandling, 2024-04-25)Med økende levealder er kognitiv sunn aldring viktig for et godt liv i alderdommen. Kognisjon hos unge voksne har økt det siste århundret, men det er få studier over tid på personer over 60 år. Risikofaktorer for kognitiv svikt og demens er identifisert, og en av de mest lovende beskyttende faktorer er fysisk aktivitet. Demensprevalensen er høyere i Norge enn sammenlignbare land, og longitudinelle ... -
Experiences with Capacity-based Mental Health Legislation in Norway. A qualitative interview study among patients who have come off a community treatment order, their health professionals and their family caregivers
(Doctoral thesis; Doktorgradsavhandling, 2024-04-26)The aim of the thesis was to explore the experiences of groups affected by the change in the Mental Health Care Act of 2017 when Norway introduced lack of consent capacity as an independent criterion for the use of coercion in mental health. Individual interviews were conducted to explore experiences with the change in the law from three perspectives in the northernmost health region of Norway. A ... -
Relationships between physical activity and chronic pain: The role of endogenous pain sensitivity - A population-based perspective: The Tromsø Study
(Doctoral thesis; Doktorgradsavhandling, 2024-04-16)<p><i>Background and aims:</i> Chronic pain is a major global health concern, yet causal mechanisms are not well understood. Physical activity is popular as prevention and treatment, possibly acting through a positive effect on endogenous pain modulation. This has not been examined in the general population. <p><i>Materials and methods:</i> We used data from the sixth and seventh surveys of the ... -
HIV Infected African Children: Gut microbiota in relation to chronic lung disease and long-term antibiotic treatment
(Doctoral thesis; Doktorgradsavhandling, 2024-04-19)More than half of the population with HIV in the world live in sub-Saharan Africa. HIV-associated chronic lung disease is the most prevalent comorbidity among children and adolescents with HIV in this region. The pathogenesis is multifactorial and thought to be a result of chronic immune activation and repeated lung injury. CD4+ T-cells are the main target for HIV infection. As the majority of CD4+ ... -
Mental Health, Work, Welfare and Vocational Rehabilitation. A Comprehensive Study of Young Adults in the Norwegian Welfare State
(Doctoral thesis; Doktorgradsavhandling, 2024-04-11)<p><i>Background:</i> Despite Norway's high living standards and robust welfare system, a paradox exists concerning its young working-age adults - low unemployment but high and increasing uptake of health-related welfare benefits, mainly due to mental health problems. My study investigates the relationship between Norway's welfare system, young adults' reliance on health-related benefits, social ... -
Educational inequality in population-based health studies
(Doctoral thesis; Doktorgradsavhandling, 2024-04-04)When comparing groups in the society, one can observed systematic differences in health. The higher the education the group has, the higher the proportion of the group’s member have good health. These differences are known as social inequality in health. Information concerning an individual’s socioeconomic status is often collected through self-administrated questionnaires within epidemiological ...


 English
English norsk
norsk